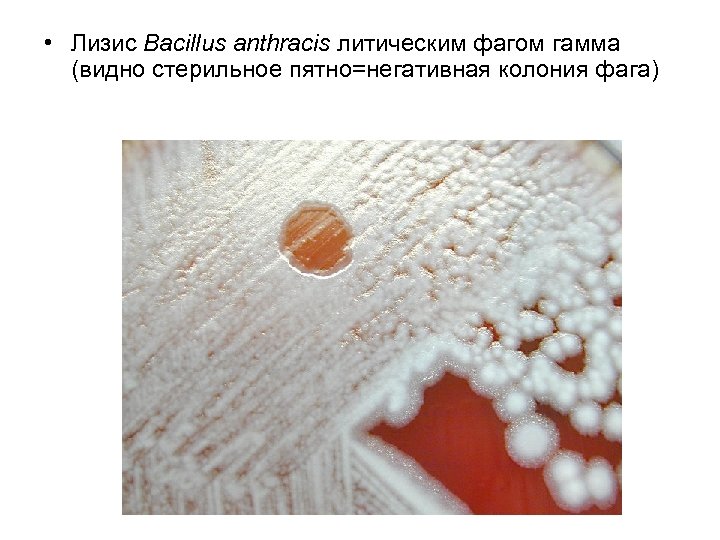
• Лизис Bacillus anthracis литическим фагом гамма (видно стерильное пятно=негативная колония фага)

30652bdb881307542a69efd2e73f2234.ppt
- Количество слайдов: 26

СИБИРСКАЯ ЯЗВА

• Сибирская язва – острая зоонозная инфекция, протекающая с тяжелой интоксикацией, серозно-геморрагическим воспалением кожи и лимфоузлов, вовлечением внутренних органов, развитием сепсиса. • Преобладает кожная форма. Значительно реже встречаются легочная и кишечная формы.

Таксономическое положение возбудителя сибирской язвы • Семейство Bacillaceae • Род Bacillus • Вид Bacillus anthracis - B. anthracis

Морфологические свойства B. anthracis • Крупные неподвижные грамположительные палочки, располагаются цепочками. • Во внешней среде образуют центрально расположенную эндоспору. • В организме образуют полипептидную капсулу.

Споры B. anthracis - окраска простым методом и по Ожешки

B. аnthracis в органах (окраска по Граму) - видна капсула

Биологические свойства • Вегетативные формы относительно малоустойчивы, споры резистентны к высоким и низким температурам, действию дезинфектантов • Факультативный аэроб • Нетребовательны к питательным средам, на средах с сывороткой образует колонии «голова медузы» • Вирулентные (капсулированные) штаммы образуют R-колонии, авирулентные – S-колонии Колонии Bacillus anthracis

Антигены 1. Группоспецифический полисахаридный термостабильный антиген, связанный с клеточной стенкой (выявляется в реакции кольцепреципитации по Асколи) 2. Видоспецифический капсульный термолабильный антиген 3. Протективный антиген сибиреязвенного токсина

Факторы патогенности B. anthracis • Капсула – обладает адгезивными и антифагоцитарными свойствами • Комплексный токсин - состоит из протективного антигена, некротического и отечного факторов

Механизм действия сибириязвенного токсина • Протективный антиген - формирует каналы в клеточной мембране макрофагов и других клеток организма • Через образовавшиеся каналы проникают летальный и отечный факторы вместе с протективным антигеном • Внутри клетки при участии протективного антигена реализуется токсическое действие обоих токсинов

Механизм действия сибириязвенного токсина • Летальный токсин – основной токсин B. anthracis • – нарушает внутриклеточный синтез макромолекул, что приводит к гибели клеток, в первую очередь макрофагов • - при гибели макрофагов выделяются цитокины (ИЛ 1, ФНО и др. ), они вызывают нарушение микроциркуляции и систему свертывания крови, может развиться инфекционно-токсический шок • Отечный токсин вызывает нарушение функции аденилатциклазной системы, что ведет к выделению воды и солей из клеток и развитие отека

Источник инфекции – домашний скот

Механизмы передачи • Контактный – при уходе за больным животным, убое, разделке туши, кулинарной обработке мяса, работой с сырьем животного происхождения • Аэрозольный - при контакте с инфицированной почвой, животноводческим сырьем (шерстью, мехом, шкурами) • Энтеральный – через молоко, молочные продукты, мясо и мясные продукты • Трансмиссивный – через слепней и мух-жигалок, в ротовом аппарате которых возбудитель может сохраняться до 5 дней • От человека человеку сибирская язва не передается

Патогенез • • • Возбудитель проникает в организм человека через кожу, слизистые оболочки дыхательных путей и, реже – через слизистую оболочку ЖКТ Инкубационный период – от нескольких часов до 3 -4 суток, но может составить 8 -14 суток В месте внедрения микроба развивается сибиреязвенный карбункул очаг серозно-геморрагического воспаления с некрозом, отеком окружающих тканей и регионарным лимфаденитом. У большинства людей патологический процесс остается локализованным в месте внедрения возбудителя. Генерализованная форма болезни чаще возникают при аэрогенном механизме заражения, когда споры возбудителя попадают на слизистые оболочки трахеи, бронхов, альвеол. Отсюда возбудитель заносится в регионарные лимфоузлы, что приводит к их деструкции. Из лимфоузлов возбудитель легко проникает в кровь, что дает начал о генерализации патологического процесса. Алиментарный путь заражения также приводит к генерализованном у течению заболевания. Клинические формы зависят от входных ворот возбудителя – кожная, легочная, кишечная формы

Кожная форма – сибиреязвенный карбункул

Иммунитет • После перенесенной сибирской язвы развивается стойкий антимикробный и антитоксический иммунитет

Специфическая профилактика и лечение • • Специфическое лечение проводят противосибиреязвенным иммуноглобулином Антибиотикотерапию проводят препаратами пенициллиновой группы, тетрациклином, аминогликозидами, ципрофлоксацином • Для активной профилактики сибирской язвы применяются: • - Вакцина живая СТИ, представляющая собой споры бескапсульного штамма B. anthracis • - Вакцина комбинированная, в состав ее входит живая вакцина СТИ и протективный антиген B. anthracis

Лабораторная диагностика сибирской язвы • Материал для исследования зависит от клинической формы заболевания: отделяемое везикул, карбункулов, язв, струпы, кровь, мокрота, испражнения, пунктат лимфоузлов и др. • • Применяемые методы исследования: - бактериоскопический - бактериологический - серологический - биологический - ПЦР - кожно-аллергический

Метод иммунофлюоресценции – экспресс-метод

МБД сибирской язвы проводится в специализированных режимных лабораториях • Бактериоскопический метод – готовят мазки, окрашивают по Граму – видны крупные грамположительные палочки, окруженные капсулой палочки,

Бактериологический метод Посев и выделение чистой культуры проводят на МПА или кровяном агаре

Идентификация чистой культуры B. anthracis • • • Изучают следующие свойства: - морфологические - культуральные - биохимические - тест «жемчужного ожерелья» (рост на МПА с пенициллином – утрата клеточной стенки приводит к образованию цепочки «бусин» • - чувствительность к сибиреязвенному бактериофагу • - вирулентность для мышей, морских свинок, кроликов
• Лизис Bacillus anthracis литическим фагом гамма (видно стерильное пятно=негативная колония фага)

Серологический метод диагностики • Выявление сибиреязвенного антигена непосредственно в патологическом материале с помощью РОНГА, ИФА, МИФ, реакции термопреципитации по Асколи • Специфические антитела в испытуемых сыворотках выявляют для ретроспективной диагностики (при кожной форме заболевания) в РНГА, ИФА

ПЦР в диагностике сибирской язвы и оборудование для постановки ПЦР • ПЦР является чувствительным экспресс-методом, позволяющем в течение нескольких часов выявить наличие ДНК B. anthracis в исследуемом материале, взятом у больного даже во время лечения антибиотиками или в объектах внешней среды

ПЦР-индикатор для полевых условий
30652bdb881307542a69efd2e73f2234.ppt